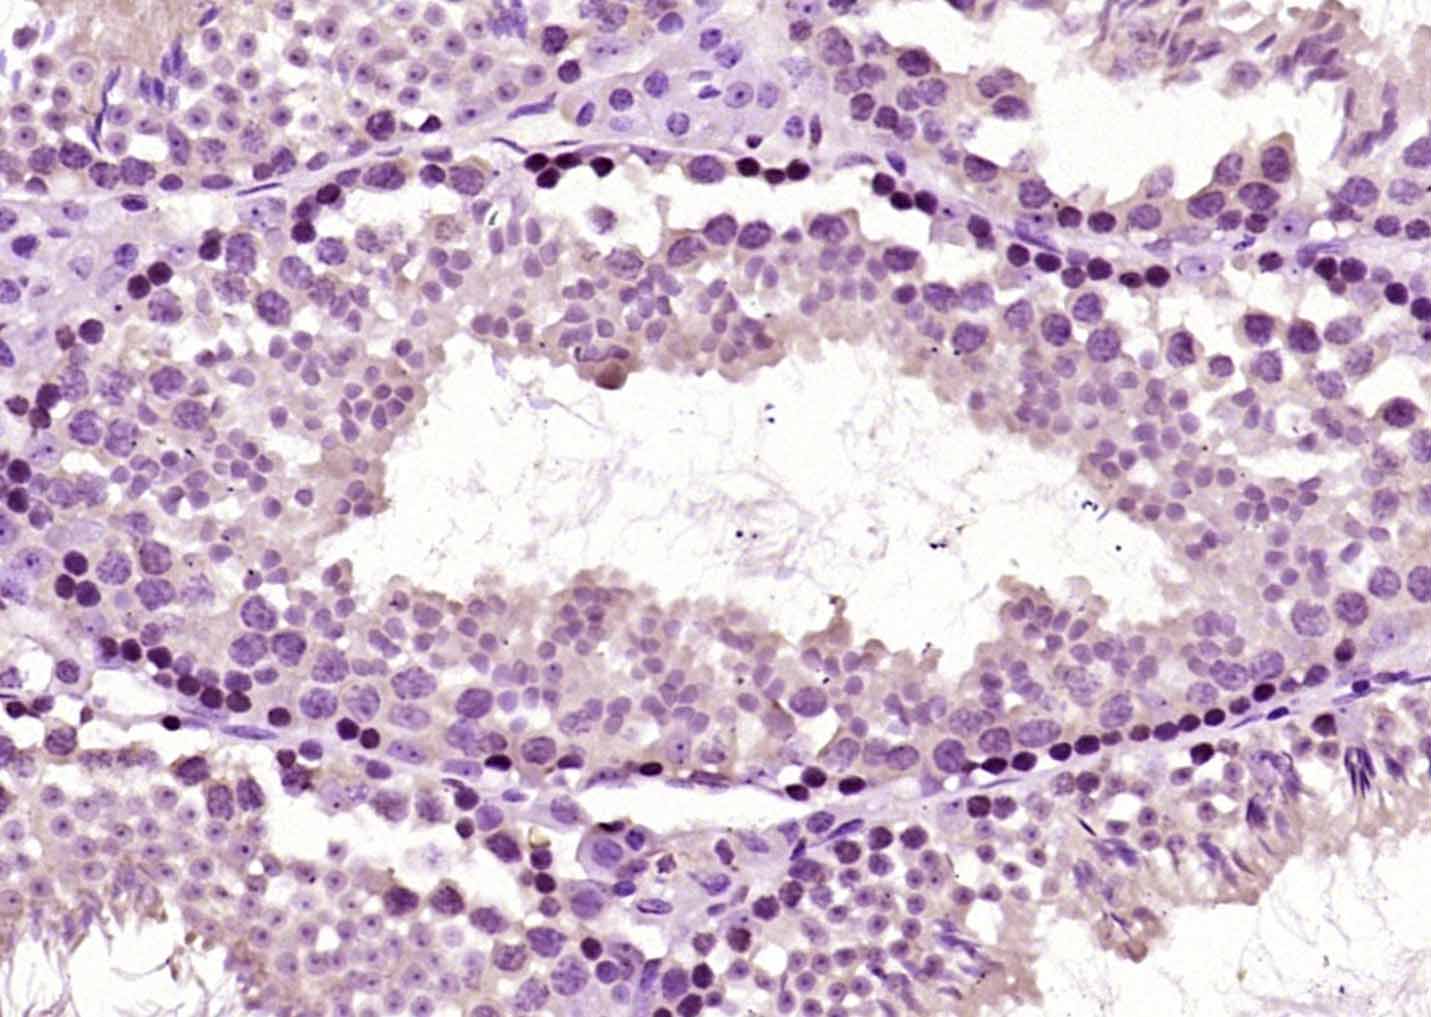
产品细节图片1

相关产品推荐更多 >
万千商家帮你免费找货
0 人在求购买到急需产品
- 详细信息
- 文献和实验
- 技术资料
- 应用范围:
产品信息以Bioss网站为准
- 规格:
50ul/100ul/200ul
| 规格: | 50ul | 产品价格: | ¥1180.0 |
|---|---|---|---|
| 规格: | 100ul | 产品价格: | ¥1980.0 |
| 规格: | 200ul | 产品价格: | ¥2800.0 |
| 产品编号 | bs-4636R |
| 英文名称 | NR2C2 Rabbit pAb |
| 中文名称 | 孤儿核受体TAK1抗体 |
| 英文别名 | NR2C2_HUMAN; Nuclear hormone receptor TR4; Nuclear receptor subfamily 2 group C member 2; Orphan nuclear receptor TAK1; Orphan nuclear receptor TR4; TAK1; Testicular nuclear receptor 4; Testicular receptor 4; TR2R1; TR4; TR4 nuclear hormone receptor. |
| 产品应用 | IHC-P=1:100-500, IHC-F=1:100-500, IF=1:100-500 Not yet tested in other applications. |
| 交叉反应 | Mouse (Human, Rat, Chicken, Dog, Cow, Horse, Rabbit) |
| 抗体来源 | Rabbit |
| 免疫原 | KLH conjugated synthetic peptide derived from human NR2C2 |
| 亚型 | IgG |
| 性状 | Liquid |
| 纯化方法 | affinity purified by Protein A |
| 克隆类型 | Polyclonal |
| 理论分子量 | 65 kDa |
| 浓度 | 1mg/ml |
| 储存液 | 0.01M TBS (pH7.4) with 1% BSA, 0.02% Proclin300 and 50% Glycerol. |
| 研究领域 | Epigenetics and Nuclear Signaling > Nuclear Signaling Pathways > Nuclear Receptors > Orphan Nuclear Receptors |
| 亚基 | Homodimer; can bind DNA as homodimer. Heterodimer; binds DNA as a heterodimer with NR2C1 required for chromatin remodeling and for binding to promoter regions such as globin DR1 repeats. Interacts with PCAF; the interaction preferentially occurs on the non-phosphorylated form and induces NR2C2-mediated transactivation activity and does not require the ligand-binding domain. Interacts (MAPK-mediated phosphorylated form) with NRIP1; the interaction promotes repression of NR2C2-mediated activity. Interacts with NR2C2AP; the interaction represses selective NR2C2-mediated transcriptional activity. Interacts with NLRP10. |
| 亚细胞定位 | Cytoplasm. Cell membrane. Translocates to the plasma membrane upon calcium binding. |
| 翻译后修饰 | Phosphorylation on Ser-19 and Ser-68 is an important regulator of NR2C2-mediated transcriptional activity. Phosphorylation on these residues recruits the corepressor, NRIP1, leading to transcripional repression, whereas the non-phosphorylated form preferentially recruits the coactivator, PCAF. |
| 相似性 | Contains 5 EF-hand domains. |
| 功能 | Regulatory subunit of the calcium-regulated non-lysosomal thiol-protease which catalyzes limited proteolysis of substrates involved in cytoskeletal remodeling and signal transduction. |
| 保存条件 | Shipped at 4℃. Store at -20℃ for one year. Avoid repeated freeze/thaw cycles. |
| 注意事项 | This product as supplied is intended for research use only, not for use in human, therapeutic or diagnostic applications. |
| 背景资料 | Orphan nuclear receptor that can act as a repressor or activator of transcription. An important repressor of nuclear recptor signaling pathways such as retinoic acid receptor, retinoid X, vitamin D3 receptor, thyroid hormone receptor and estrogen receptor pathways. May regulate gene expression during the late phase of spermatogenesis. Together with NR2C1, forms the core of the DRED (direct repeat erythroid-definitive) complex that represses embryonic and fetal globin transcription including that of GATA1. Binds to hormone response elements (HREs) consisting of two 5'-AGGTCA-3' half site direct repeat consensus sequences. Plays a fundamental role in early embryonic development and embryonic stem cells. Required for normal spermatogenesis and cerebellum development. Appears to be important for neurodevelopmentally regulated behavior. Activates transcriptional activity of LHCG. Antagonist of PPARA-mediated transactivation. |
| 应用 | 推荐稀释比例 |
| {IHC-P} | {1:100-500} |
| {IHC-F} | {1:100-500} |
| {IF} | {1:100-500} |

风险提示:丁香通仅作为第三方平台,为商家信息发布提供平台空间。用户咨询产品时请注意保护个人信息及财产安全,合理判断,谨慎选购商品,商家和用户对交易行为负责。对于医疗器械类产品,请先查证核实企业经营资质和医疗器械产品注册证情况。
文献和实验= NAL), appears to form upon oxidative cyclization of the nonfluorescent 2:1 lysine-HNE Michael adduct-Schiff base cross-link (Scheme 1). Polyclonal antibody (PAb) to the NAL-HNE fluorophore was raised in rabbit and found to be highly specific
GE Healthcare Benzamidine Sepharose™ 6B is p-aminobenzamidine covalently attached to Sepharose 6B by the epoxy coupling method. p-Aminobenzamidine (PAB), is a synthetic inhibitor of trypsin-like serine protease. Trypsin and trypsin
as a heterogeneous ligand system for enhanced endothelial cell adhesion. J. Biomed. Mater. Res. 41, 377-385, doi:10.1002/(SICI)1097-4636(19980905)41:33.0.CO;2-9 [pii] (1998). 2. Broxmeyer, H.E., et al. Cord blood stem and progenitor cells. Methods Enzymol
技术资料暂无技术资料 索取技术资料









